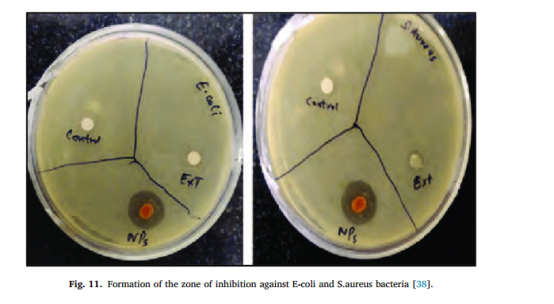

人工纳米膜在纳米技术背景下的重要性与应用

文、编辑 | 鹏老
抗菌纳米纤维是一种独特的领域,它结合了纳米纤维的特性和生物杀灭作用。
聚合纳米纤维可以通过几种方式制造,例如通过绘图,使用模板,分离相,或者让它们自己组合在一起。

纳米膜的制造过程用于生产许多不同种类的聚合物。
静电纺丝从一个装满现成溶液的注射器、一个金属针、一个高压电源和一个金属收集器开始。

在这种方法中,聚合物溶液的稳定流动与针尖处的高压电场相互作用,针尖直接连接到电源。
这篇综述的目的是强调人工纳米膜在纳米技术背景下的重要性,并介绍功能化纳米膜的生物工程应用。

纳米膜的种类
随着纳米材料的快速发展,纳米膜变得越来越重要。在科学文献中,“纳米膜”一词的定义不同。因此,目前还没有普遍认可的定义。
例如,Kunitake及其同事提出了独立式纳米膜的概念,这有助于理清纳米膜的发育过程。

近年来,用于制备纳米或微米级纤维的天然和合成聚合物非常受欢迎。
随着纳米和微纤维膜的这些改进,更多的这些纤维可以被制造出来,并用于广泛的生物应用,如组织工程、伤口护理和将蛋白质送入体内。

由于它们的制作方法,由天然生物材料制成的纳米和微纤维膜有更多的用途。它们是:
(1)在亚微米尺度上增加孔隙度
(2)生物相容性。
(3)细菌种类屏障效应。
(4)合理的机械稳定性。

膜的功能由两个因素决定:通量和选择性。膜的表面特征区分了可以通过它的物种的类型,这被称为选择性。
enm可以通过改变其去除杂质的选择性、机械强度和孔隙率来提高效率。通过表面改性提高了enm的过滤效率。

物质通过膜的速度被称为通量。孔径、湿性、孔隙度、扭曲度、跨膜压降、膜厚度都是影响这两个因素的因素。

图1说明了纳米膜根据它们的分类在随后的文本中讨论。膜的性质是不同的,它们被用于不同的应用,这取决于所用成分的化学成分。

纳米膜的合成
1、阳极化
在阳极氧化过程中,需要在铝的上面加一层。用于制造阳极层的电压会改变其性能,如阻挡层的厚度和孔隙的大小。

电压和电流也会改变铝表面的外观。电抛光利用低电压和强电流。当电压升高、电流减小时,多孔层形成。
当电流低而电压高时,就会形成一层厚厚的氧化铝。在电场中对铝进行阳极氧化的酸溶液随着时间的推移会产生阳极氧化铝图案。阳极氧化过程的工作方式如图2所示。

2、平版印刷术
光刻技术广泛应用于各行各业。如今,以优异的分辨率获得微小的特征是目标。因此,为了在纳米膜的制造中获得更好的效果,需要对光刻技术进行更深入的研究。

光刻技术有两种:掩模光刻和无掩模光刻。在掩模光刻中,掩模用于在基材上转移图案。
在无掩模光刻中,通过连续书写(不使用掩模)生成各种设计。

遮罩方法的例子有照相光刻(最小特征尺寸2-3毫米)和纳米压印光刻(最小特征尺寸6-40纳米)。
此外,电子束光刻(最小特征尺寸为5nm)是无掩膜方法的一个例子。光刻、纳米压印和电子束光刻的基本步骤示意图如图3所示。

3、化学气相沉积
在CVD中,固体加热器表面是由于气相中发生的化学反应而形成的。在化学气相沉积过程中,前驱体在高温下分解气态原子,然后吸附并沉积在衬底上。该过程如图4所示。

因此,化学气相沉积可产生各种氧化物(铁、锡、钛)、聚合物、聚噻吩、聚苯胺等纳米多孔材料、半导体(二硫化钼)、金属合金(铂-钴)等纳米多孔材料。

4、层一层的沉积
层接层沉积是另一种制备纳米膜的方法,它涉及各种带电分子的吸附。
例如,将衬底浸入阳离子聚电解质溶液中。聚电解质被吸附在厚度约为1nm的单分子薄片上。

之后,晶圆饼被清洗和干燥。稀释的聚阴离子分散液也用于浸没抛光涂层的基材。在先前放置的图层上,创建了一个新的单声道图层。

之后,晶圆片被再次清洗和干燥。为了获得所需的层数,用相同或替代材料重复该技术。
多层是通过逐层沉积形成的。厚度范围从5纳米到500纳米以上。图5显示了逐层沉积。

5、溶胶-凝胶法处理
溶胶-凝胶法制备多种纳米膜。湿法化学过程的四个主要形成步骤如下:在第一阶段必须首先产生盐或金属均匀溶液。

均质溶液的浓度必须在第二阶段增加。凝胶在第三步通过冷凝形成。最后一步是让凝胶变干。
纳米膜的质量取决于溶液的化学浓度、离心过程、温度和冷却过程。利用溶胶-凝胶技术可以制造出具有优异的电学、光学、热学、磁性和机械性能的结构。

这种方法可以应用于广泛的材料,包括金属氧化物和聚合物,以创建纳米膜。图6显示了溶胶-凝胶过程。

6、3D打印工艺
3D打印纳米膜是膜研究的一个快速发展的领域。双光子聚合产生最高分辨率的膜。

增材制造,通常被称为3D打印,可以在各种材料中创建复杂多样的几何设计。材料连接发生在被称为3D打印的逐层生产过程中。
符合ISO/ASTM国际标准。增材制造工艺有七大类:
粘结剂喷射技术、定向能沉积、材料挤出打印、材料喷射技术、粉末床熔融、片材层压和还原光聚合。

3D打印纳米膜的研究是膜科学的一个令人兴奋和发展的领域。双光子聚合产生的膜具有最好的分辨率。分辨率大约是100纳米。

该技术是基于两个光子被透明树脂吸收。3D打印纳米膜的过程如图7所示。

纳米膜的表征
1、纳米膜的FTIR分析
傅里叶变换红外光谱在4000-400 cm1范围内对生成的纳米膜(cm1)进行化学评价。图8为FTIR光谱。

FTIR分析技术用于确定样品中存在的各种官能团。结果表明,样品中含有相当数量的键。
在本研究中,使用IR-Prestige 21 设备测定包覆样品的有机无机和聚合物化合物。样品在400 cm-1 ~ 4000 cm-1波数范围内进行分析。

2、纳米膜的XRD分析
采用Mini Flex x射线衍射仪进行x射线衍射(XRD)检查,确定样品的纯度和晶体性质。
图9纳米膜阵列的XRD图谱。x射线衍射是一种无损技术,它是在达卡的BCSIR进行的。

通过研究一束x射线如何由于晶体的晶体结构而衍射,x射线晶体学被用来揭示晶体的原子和分子结构。

晶体学家可以通过测量这些衍射光束的角度和强度来创建晶体内电子密度的三维图像。
利用这种电子密度,就有可能计算出晶体中原子的平均位置,以及它们的化学键、晶体学紊乱和其他有关它们的信息。

3、纳米膜的SEM-EDX分析
利用扫描电子显微镜对合成的纳米膜的形状和分散性进行了SEM-EDX测试。
图10描绘了最终产品的形态结构。形貌、形貌、缺陷、元素组成和晶体学信息都用场发射扫描电子显微镜检查。

在本研究中,使用JSM-7610F (FESEM)仪器来检查涂层样品的形貌。本研究使用的放大倍率范围为25X至50000X,样品间距为1mm至100nm。

4、纳米膜的抗菌试验分析
利用圆盘扩散法评估了电纺丝纳米纤维膜的抑制区,并测定了其对金黄色葡萄球菌和大肠杆菌细菌的抑菌效果(图11)。

提取物或纯化学品的体外抗菌活性可以使用各种实验室程序进行评估或筛选。圆盘扩散和琼脂稀释是最流行和最基本的方法。
直接检测抗生素对细菌生长的影响可以通过将病原体和抗生素混合在一个生长环境中来完成,比如琼脂装满营养物质的盘子或试管。

抗菌试验对于检测和筛选各种物质对微生物的抑制作用至关重要,然后才能建立其抑制谱。
5、纳米膜的MMT分析
水分管理质量是多维织物液体水分传输特性,对人类对水分感觉的感知有重大影响。
一种新的方法和仪器被称为水分管理测试仪,以检查纺织品的水分管理性能。

这种新方法可用于测量织物中液体水分在多个方向上的转移,在一个步骤中,液体水分在织物表面扩散并从一个转移到另一个。利用水分管理测试仪对水分管理质量进行了测量。

利用该标准分析了润湿时间、吸收率、润湿面积的最大半径以及内外表面的扩散速度,根据纳米膜与液体的相互作用能力来识别纳米膜。

R和总体水分管理能力也进行了研究。图12样品处理水分的能力。

实验结论
纳米膜可以根据其独特的特性和制造方法分为不同的类别,因为材料、工艺或孔隙度会影响纳米膜的机械性能。
其中一个分歧与纳米膜的制造方式有关。此外,制备纳米膜的最佳方法应在考虑孔隙度、强度、渗透性、化学稳定性和热稳定性等因素后选择。

在继续进行昂贵的研究之前,有必要了解纳米膜在过去十年中取得的进展的基本概念和来源。因此,我们尽可能多地对合成纳米膜进行了综述和分类。

如溶胶-凝胶加工、化学气相沉积、逐层沉积、光刻、阳极氧化、微加工等。制造技术不断发展,以产生更高质量和机械强度的纳米膜。
正因为如此,纳米膜技术在生物工程领域,如组织工程和药物输送系统,仍然面临着许多障碍和机会。

纳米膜的机械强度和生物相容性之间的关系将取决于创新、新材料的选择、技术的可扩展性和可持续性。本文对纳米膜在生物工程领域的研究进展作一综述。
参考文献
[1]F. Russo, R. Castro-Munoz, S. Santoro, F. galliano, A。电纺丝膜在空气过滤中的应用研究进展,环境科学与技术,2002,22 (4):444 - 444。
[2]丁晓霞,赵丽丽,王志军,岳磊,张勇,壳聚糖接枝精油的合成、表征及应用前景研究,化学工程学报,2012,12,20011。
[3]刘艳,等,电纺丝金属-有机框架纳米纤维及其在废水处理中的应用研究进展,vol . 25, 2002,19 (9): 974 - 974。
[4]S. Thanigaivel。纳米生物技术在污水处理中的应用研究:基于纳米生物技术的污水处理技术研究,环境科学,2002,22(4):344 - 344。
[5]L. Spagnuolo, R. D'Orsi, A.J.C. Operamolla,纳米纤维素在造纸涂料中的应用,高分子材料学报,2003,21(4):444 - 444。
